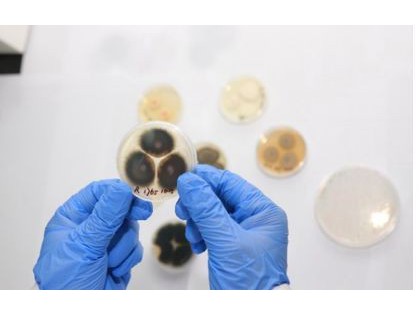

成立于2015年的慕恩生物聚焦于自然驱动的创新,开发利用最有益于作物生长的微生物,经过实验室、温室及大田筛选,结合先进的基因组分析方法及生物信息学,引入新的微生物产品,重建植物健康微生物组。
近日,35斗采访了慕恩生物创始人兼CEO蒋先芝博士,听他讲述了慕恩生物如何“以微生物重建绿色未来”。
实力与时机,缺一不可
作为中科院微生物研究所博士,蒋先芝曾发表多篇研究论文,申请国际发明专利十余项。博士在读期间,他主要研究如何利用微生物防治线虫。植物寄生线虫会破坏植物根部组织,或者以植物为食的时候传染植物病毒,对农作物造成巨大经济损失。
2010年,蒋先芝加入诺维信公司担任高级科学家,负责微生物及新酶筛选,并获得2010年、2012年度诺维信总裁奖。由于长期从事微生物资源的发掘、筛选和应用开发,蒋先芝既有丰富的学术研究背景又有完整的产业化经历。

慕恩生物创始人兼CEO蒋先芝博士
谈到创办慕恩生物的契机,蒋先芝表示这是自己的兴趣所在,从本硕博到工作创业,近20年时间里,他都在和微生物打交道,一直想往实际应用和产业化方向发展。
从2010年开始,微生物行业发展十分迅速,在多个领域的应用也不断拓展。近几年,多组学技术的进步和研究的积累,推动了产业化节点的到来,微生物已经成为生物科技领域的一大热点。
在国外,微生物产业正处于飞速发展阶段,而在国内,传统的微生物公司基本以销售和市场为主导,缺乏创新能力和掌握产业化核心技术的人才。所以,慕恩生物利用早期创业团队的产业化背景和技术优势,开拓国内微生物市场。
创立之初,慕恩生物核心团队便专注于微生物资源的发掘和应用,包括菌株的采集、分离培养、高效筛选、发酵优化、剂型研制。在生物农业方面, 核心成员由来自全球知名高校、跨国生物技术公司以及国内领先科研院所的青年科学家组成,团队具有丰富的产品研发和产业化运作经验。
35斗了解到,截至2019年7月,慕恩生物的微生物菌株数量已超过8万株,其中包括很多全球首次发现的新菌株资源。预计到2019年12月,这一数量将达到10万。目前,慕恩生物是全球规模最大、生物多样性最高的商业化微生物资源中心之一。
对于如何发掘到这么多资源,蒋先芝表示,这得益于整个团队的技术积累,也是慕恩生物的核心竞争力之一,公司要求每一位研发人员都要参与资源发掘的工作。团队已经采集了国内25个省市的2万多份作物相关样本,包括种子样本、作物样本、根际土壤的样本等,而慕恩生物的菌群培养技术在国际上也是较为领先的。
如何破局微生物资源商业化?
慕恩生物定位于微生物资源商业化的创新型生物技术公司。“整个微生物产业的核心,在于怎么发掘微生物资源,并实现产业化。在国内,特别是农业领域,早期做菌种研发的公司非常少,一般是通过研究所、学校引进或购入菌株。但问题在于,通常情况下,这些菌株并没有经过严格的筛选和评估。”蒋先芝向35斗记者解释道。
慕恩生物从这一行业痛点出发,聚焦菌种研发和产业化。依靠Culture-To-Product研发平台,通过国际领先的(有氧和厌氧)微生物分离和培养技术,发现、保存、鉴定极具开发价值的微生物资源。
Culture-To-Product平台从微生物资源挖掘,到活性筛选、应用测试、剂型研制,再到工业化生产都拥有技术优势,可为客户提供专业的微生物产品和解决方案。
慕恩生物研发平台的特点在于,这是一个纯产业化的平台,资源挖掘、菌群培养、高通量筛选、发酵优化、剂型开发五大环节,共同形成了完整的技术体系。慕恩生物早期聚焦于菌种发掘,现在技术平台已经往下游延伸,寻求更多的应用落地。搭建从菌株到产品的完整研发平台,也是慕恩生物的优势之一。

(发酵平台,图片来源:慕恩生物)
基于Culture-To-Product研发平台,慕恩生物主要业务分为生物医药和生物农业两大板块。针对农业领域,慕恩生物设立了阶段性目标,目前的发展方向以及产品线都围绕种子处理进行。
蒋先芝进一步说道,“种子处理只是应用方式之一,其他应用还包括高效的微生物肥料、农药等。已有的微生物肥料或微生物农药产品比较雷同,慕恩生物的核心价值是希望研发创新型产品,对标国外一线生物技术公司,用最先进的技术和理念打造一流产品。比如解磷微生物,即如何利用微生物提高作物对土壤磷元素的吸收,慕恩生物已经完成对上万株解磷微生物的筛选评价。”
目前,慕恩生物在登记的农业微生物产品有12个,其中4个微生物肥料产品已经获得产品证件,到2019年底,预计会有8个产品上市。
此外,慕恩生物推出的真菌系列产品已经处于国内领先地位。产品研发方向在于如何防治作物的细菌性病害或真菌性病害,以及其他土传病害。另一个重点方向是如何通过微生物提高作物的抗逆能力,比如抗干旱能力,让作物在干旱环境下,能保持高产量和良好的生存能力。
激发农业新增市场活力
商业模式方面,慕恩生物聚焦To B业务,核心价值在于研发、生产和产品授权。在种子处理领域,慕恩生物主要关注大田作物,比如水稻、小麦、大豆等,通过种子公司的渠道推广微生物产品。

(田间试验基地,图片来源:慕恩生物)
在生物肥料、生物农药领域,慕恩生物关注高附加值的经济作物,包括高端蔬菜水果、设施作物、中药材等,这一方面主要和国内的大型农药、肥料公司合作。

(温室盆栽实验,图片来源:慕恩生物)
对于微生物农业的发展,蒋先芝表示,可以从两个维度来看,首先是存量市场,固氮菌、解磷菌、Bt等都属于传统应用。慕恩生物利用技术优势,通过发掘更高效的菌种、优化提高发酵得率、研制更稳定的剂型、改善微生物产品的兼容性等方式,提高竞争力,并将微生物用在种子处理、土壤改良等细分领域上,快速扩大存量市场的市场容量。
另一方面,慕恩生物更看好的是未来的增量市场,认为其有广阔的发展空间,市场大小可能是传统微生物农业的数十倍。“以人体肠道微生物为例,我们以前开发利用的肠道微生物仅仅局限于少数的乳酸菌类,功能单一。近几年,科学家发现肠道微生物与许多重要疾病有密切关联,在这些疾病的治疗上可以发挥巨大潜力。”
“我们对农业微生物功能的认识也将取得极大的发展,比如,国外的Indigo公司利用微生物提高作物抗干旱性能,这类产品也属于增量市场。以前的产品和功能非常单一,随着技术的进步,发掘新物种、新菌种和新产品研发能力大大提高,微生物学家有能力设计出更多的创新产品。”蒋先芝解释道。
除了团队拥有资深的产业化背景和领先的技术外,蒋先芝认为,慕恩生物的另一大优势在于对产业的深刻认识上。摸清产业脉搏、预判未来趋势、深度理解技术,都是慕恩生物的核心竞争力。
自2015年成立以来,慕恩生物扎根微生物产业,对接了很多优质资源。首先是学术资源,慕恩生物与中科院、农科院、各大高校等学术单位都建立了密切合作关系。其次是对接了优质的产业化公司,包括国内外大型的农药和肥料公司。
35斗了解到,慕恩生物此前完成了两轮融资。年底前会完成新一轮融资,交易金额为1亿人民币到1.5亿人民币。

(数据来源:慕恩生物,35斗整理)
谈到之后的发展规划,蒋先芝表示,“慕恩生物目前聚焦种植业,利用作物的微生物组解决农业面临的突出问题,比如找到减少或者替代化学农药、化学肥料的方法,让作物更加有机、环保、绿色。我们也希望与国内较大的种子公司进行合作,共同开发和推广微生物种子处理的应用。在养殖业方面,慕恩生物也与合作伙伴展开了前期工作,比如与南京金斯瑞的产品研发合作计划预计今年会很快落地。”
未来,慕恩生物将继续运用生物创新帮助解决环境、农业、疾病治疗等问题,为客户提供全球领先的微生物产品和服务。